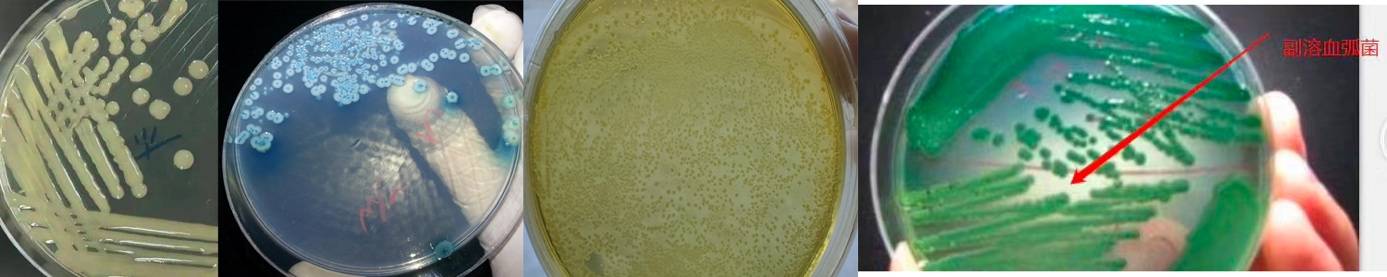

在虾类养殖业中,我们经常使用弧菌培养皿来检测弧菌的类型和数量,特别是黄弧菌和绿弧菌,其中包括了副溶血弧菌、河流弧菌(绿弧菌)以及溶藻弧菌、霍乱弧菌、哈维氏弧菌和鳗弧菌(黄弧菌)。
绿弧菌和黄弧菌
绿弧菌和黄弧菌
那么,这些弧菌究竟对虾类养殖有何危害呢?研究表明,其中副溶血弧菌是最具威胁性的。感染初期,可能出现红腿红尾等症状,接着可能引发肠炎、肝脏疾病,严重时甚至导致虾类罹患菌血症红体病。哈维氏弧菌感染则表现为幼虫在临近死亡前发光。而霍乱弧菌感染则可引发虾类失明。
弧菌主要通过口腔摄入途径传播,其次是通过体表创伤和腮部进入虾体。
 蛭弧菌演变图
蛭弧菌演变图
我们在水产业中采用以下三种方法来控制弧菌:
1. 消毒:我们可以使用诸如塘宁散等消毒方法,快速而有效地杀灭水中的弧菌。一般养殖面积比较大,弧菌感染严重超标,可以优先使用塘宁散,大概10小时后再使用我们的“蛭弧菌”,很快就可以控制弧菌了。
 塘宁散
塘宁散
2. 蛭弧菌:以菌治菌的方式,通过使用蛭弧菌来预防和控制弧菌感染。我们的“蛭弧菌”产品是美国巴斯德公司多年科研成果,它采用的是美国先进的微生物驯化技术,根据当季度流行性致病性副溶血弧菌、哈维氏弧菌、海洋弧菌、溶藻弧菌、霍乱弧菌的流行菌株定向驯化,能够快速精准的识别并裂解当前流行性致病弧菌,可大幅降低弧菌检出率。蛭弧菌是应对弧菌超标问题的理想选择,有助于维护虾类养殖业的健康和可持续发展。
 蛭弧菌
蛭弧菌
3. 有益菌的使用:研究表明,当水中的弧菌数量超过理论阀值时,如果水中总异养菌的数量达到弧菌数量的30倍以上,虾类仍然相对安全。因此,我们可以定期添加有益菌,如乳酸菌和复合丁酸梭菌等,通过数量上的竞争来抑制弧菌的繁殖。
 复合丁酸梭菌
复合丁酸梭菌
要控制虾体内的弧菌,有两种主要方法:
1. 控制水中的弧菌:虾类的消化道与水体密切相关,水中的微生物组成会直接影响虾类的肠道微生物。因此,通过减少水中的弧菌数量,可以有效地预防肠道弧菌感染。这可以通过在水中添加蛭弧菌或将有益菌拌入饲料中来实现。
 US·Pasteur 蛭弧菌
US·Pasteur 蛭弧菌
2. 利用有益菌:通过将乳酸菌或复合丁酸梭菌添加到饲料中,或者通过泼洒的方式,有助于建立有益菌在虾类肠道内的优势群落。这些有益菌将附着在肠道壁上,形成一种生物屏障,使弧菌难以粘附在肠道壁上,从而降低感染的风险。
在虾类养殖业中,弧菌问题一直备受关注,但通过上述的控制策略,我们可以更加自信地应对这一挑战。从水体的消毒到有益菌的应用,以及对虾体内弧菌的控制,这些方法共同构筑了一道坚固的屏障,维护了虾类养殖业的健康和可持续发展。
作为专注于水产养殖解决方案的领先企业,我们的公司致力于为养殖业提供高效、可靠的产品和服务。如果您需要了解更多关于我们的“蛭弧菌”产品以及如何改善虾类养殖业的信息,请随时联系我们的专家团队。我们期待着与您合作,共同打造一个繁荣的水产养殖产业。
